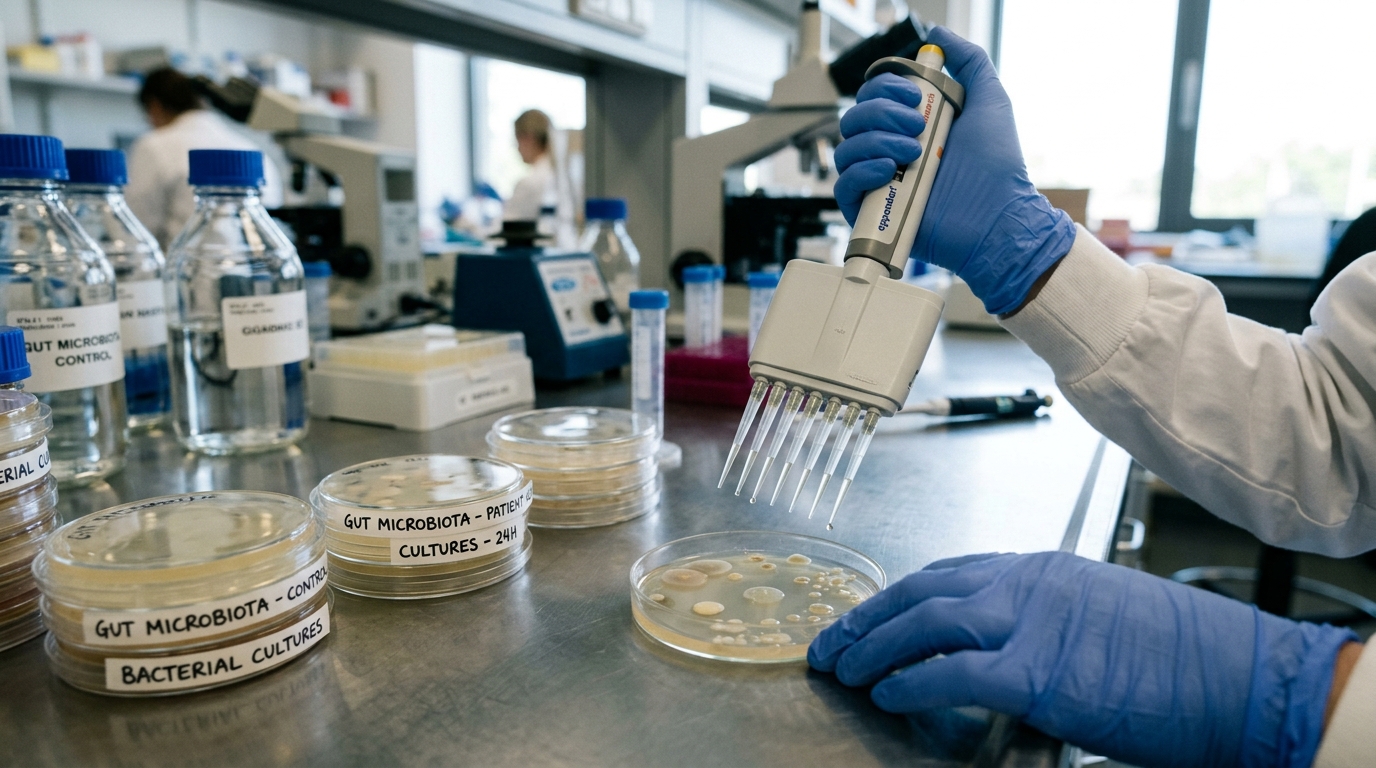
Boîtes de Petri du microbiote intestinal en laboratoire

En Chine, le microbiote intestinal ouvre une nouvelle voie pour l’innovation pharmaceutique
En Chine, la recherche sur le microbiote intestinal s’impose comme un moteur d’innovation pharmaceutique. Des experts réunis à Pékin estiment que les avancées sur l’écologie du microbiome créent de nouvelles opportunités pour concevoir des médicaments et des produits de santé, tout en facilitant le passage du laboratoire au marché. Dans cette dynamique, l’intelligence artificielle et les approches multi-omiques deviennent des leviers essentiels pour accélérer la transformation industrielle.
Pourquoi le microbiote intestinal change la donne pour les médicaments
Quinze ans de recherche ont suffi pour établir des liens solides entre le microbiote intestinal et un large éventail de maladies : troubles métaboliques, maladies cardiovasculaires, pathologies auto-immunes, certains cancers. Ce corpus de connaissances ouvre un champ d’innovation considérable pour des traitements qui agissent directement au niveau de l’intestin.
Un fait mérite attention : certains médicaments n’ont pas besoin de passer dans le sang pour être efficaces. Ils peuvent interagir directement avec le microbiote dans l’intestin et déclencher des effets thérapeutiques de manière locale. Mieux encore, des molécules faiblement absorbées peuvent être transformées par les microbes en composés actifs, ce qui renforce leur efficacité clinique.
- Près de 15 ans de recherche sur le lien microbiote-maladies
- 4 grands domaines pathologiques concernés : métaboliques, cardiovasculaires, auto-immunes, cancer
- 1 forum dédié au microbiome tenu à Pékin
- 2 leviers technologiques intégrés : multi-omiques et IA
- La Chine renforce sa stratégie d’innovation biopharmaceutique et cherche à mieux valoriser ses découvertes scientifiques.
- Le microbiome est devenu un axe prioritaire pour générer de nouveaux candidats médicaments et produits de santé.
- La recherche ouvre aussi des pistes pour moderniser la médecine traditionnelle chinoise sur des bases scientifiques solides.
Agir dans l’intestin : un nouveau paradigme thérapeutique
La capacité de certaines molécules à agir sans transiter par le sang rebat les cartes de la pharmacologie. En s’appuyant sur le microbiote intestinal, les chercheurs peuvent désormais cibler des mécanismes locaux, exploiter des voies métaboliques microbiennes et envisager des stratégies thérapeutiques plus précises.
Les experts soulèvent une autre perspective : des médicaments jusqu’ici limités par une faible absorption orale pourraient voir leur efficacité renforcée grâce aux transformations biochimiques opérées par la flore intestinale. Moduler ces équilibres microbiens pourrait ainsi devenir un axe d’optimisation à part entière pour les traitements de demain.
Relire la médecine traditionnelle chinoise à la lumière du microbiome
La médecine traditionnelle chinoise (MTC) est elle aussi concernée. Des chercheurs avancent que l’efficacité de certains remèdes pris par voie orale s’expliquerait en partie par leurs interactions précoces avec les microbes intestinaux, avant même d’entrer dans la circulation sanguine. Ces interactions peuvent modifier la structure des composés, leur efficacité, leur profil pharmacocinétique et, dans certains cas, leur toxicité.
Ce cadre scientifique permet de mieux comprendre des observations cliniques solides mais longtemps inexpliquées. Il ouvre aussi une voie pour moderniser la MTC selon des standards analytiques et cliniques compatibles avec les exigences actuelles de l’industrie pharmaceutique.
De la découverte à l’usine : les obstacles à lever
Malgré cet élan, plusieurs verrous freinent encore la traduction industrielle. Des experts pointent un manque de souches bactériennes propriétaires – indispensables pour construire des actifs différenciants – ainsi que des standards d’évaluation encore incomplets. À cela s’ajoute l’instabilité des productions à l’échelle pilote, qui limite la montée en puissance vers l’industrialisation.
Concrètement, ces lacunes rendent difficile la standardisation de la qualité, la reproductibilité des lots et l’évaluation harmonisée de l’efficacité et de la sécurité des produits liés au microbiome. Sans progrès sur ces fronts, la chaîne de valeur industrielle restera incomplète.
IA et multi-omiques : accélérer la R&D et la transformation industrielle
Pour gagner en vitesse et en fiabilité, un centre national de développement de nouveaux médicaments explore l’intégration des approches multi-omiques – qui combinent données génomiques, métagénomiques et métabolomiques – avec l’intelligence artificielle. L’objectif : construire des modèles de microbiome, des bases d’interactions et des plateformes translationnelles capables de soutenir l’ensemble du pipeline de recherche.
En pratique, cette intégration vise à accélérer l’identification de cibles microbiennes, à affiner la prédiction des interactions médicament-microbiote et à sécuriser le passage des preuves de concept vers des candidats industrialisables. Elle doit aussi renforcer les capacités de production à l’échelle pilote, maillon souvent fragile de la chaîne.

Ce que cela change pour l’écosystème pharma chinois
L’enjeu dépasse la seule découverte de nouveaux composés. En s’appuyant sur le microbiote intestinal, la Chine cherche à consolider une filière intégrée : recherche, évaluation, production pilote, valorisation. Les institutions visent à convertir ces avancées en candidats médicaments et en produits de santé concrets, dans le cadre de l’initiative Healthy China.
Cette trajectoire peut favoriser la montée en gamme industrielle tout en offrant de nouvelles solutions pour des maladies complexes. La clé sera d’aligner science, normes d’évaluation et capacités de production pour garantir qualité, sécurité et efficacité des futures générations de produits liés au microbiome.
- Le microbiote intestinal est lié à de grandes familles de maladies et devient une cible centrale de R&D.
- Des médicaments peuvent agir localement dans l’intestin ou être activés par des microbes, sans passer par le sang.
- Des obstacles persistent : souches propriétaires limitées, standards incomplets, instabilité à l’échelle pilote.
- L’intégration multi-omiques + IA vise à accélérer la recherche et la transformation industrielle.
Vers une nouvelle génération de thérapies centrées sur le microbiote
Les avancées en Chine traduisent une ambition claire : faire du microbiome un pilier de l’innovation pharmaceutique et de la modernisation de la santé. Si les verrous industriels sont levés, elles pourraient conduire à des traitements plus ciblés, à une meilleure exploitation des médicaments oraux et à une relecture scientifique de la MTC. Qu’en pensez-vous : le microbiote peut-il devenir la prochaine frontière de l’innovation thérapeutique en Chine ? Partagez votre avis en commentaire.
Sources : ECNS
